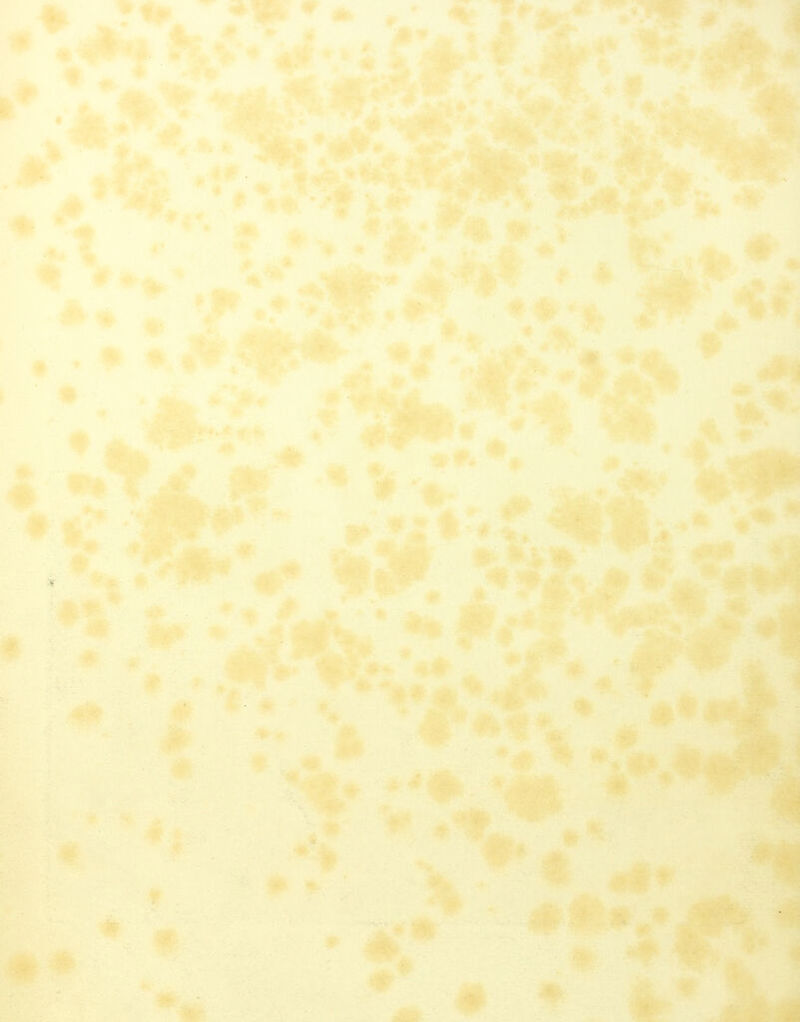
No text description is available for this image

Atlas der pathologischen Histologie des Auges / unter mitwirkung des Herrn Prof. Dr. C. Stellwag von Carion ; herausgegeben von C. Wedl.
- Karl Stellwag von Carion
- Date:
- 1861
Licence: Public Domain Mark
Credit: Atlas der pathologischen Histologie des Auges / unter mitwirkung des Herrn Prof. Dr. C. Stellwag von Carion ; herausgegeben von C. Wedl. Source: Wellcome Collection.
Provider: This material has been provided by UCL Library Services. The original may be consulted at UCL (University College London)
40/114